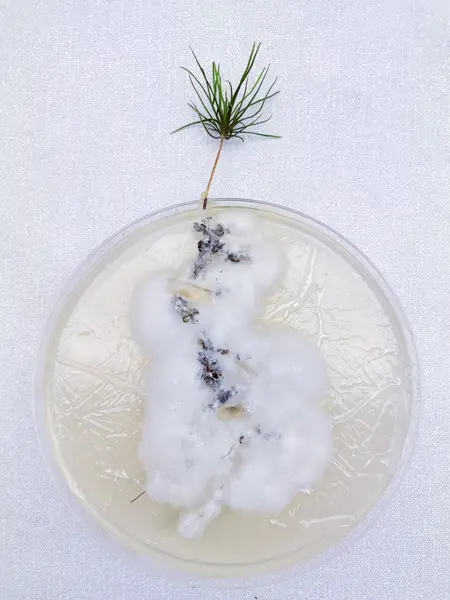
A pine seedling with fungal mycelium at the roots grows in a round plastic container. Photo.

Beneath the pines: how fungi drive forest nutrient cycles
In her new doctoral thesis, Katharine King shows how ectomycorrhizal fungi drive nutrient cycling in the forest by linking mineral weathering and nitrogen mobilisation, which supports tree growth and keeps the ecosystem healthy.
Beneath the pines and spruces of the northern boreal forests, an unseen workforce is quietly at work. A type of soil living fungi, known as ectomycorrhizal fungi, form intimate partnerships with tree roots, exchanging essential nutrients such as nitrogen and base cations for energy-rich sugars. Ectomycorrhizal fungi are known for their abilities to mobilize nitrogen and weather minerals, but the precise mechanisms behind these processes—and how they interact—have remained largely unexplored.
A new doctoral thesis by Katharine King sheds light on how these microscopic organisms shape forest health—and, indirectly, the global climate.
More than passive nutrient gatherers
Katharine’s research, conducted over several years of fieldwork and laboratory experiments, reveals that these fungi are more than passive nutrient gatherers. They actively break down minerals in the soil, releasing magnesium and other nutrients that the trees absorb to grow. At the same time, ectomycorrhizal fungi help mobilize nitrogen from organic matter, a crucial nutrient for plant development. Two fungal species—Suillus bovinus and Piloderma sphaerosporum—were most common in soil layers where mineral weathering and nitrogen mobilisation take place.

– We also looked at how the fungus Suillus bovinus adjusts its nutrient-gathering when growing with minerals. We found that several genes helping the fungus take up important minerals became more active, and many of these genes belong to rapidly evolving gene families—showing how the fungus can adapt to get the nutrients it needs, says Katharine.
A nutrient feedback loop between trees and fungi
Katharine’s research also shows that trees with access to more nitrogen-rich organic matter grow larger and supply more sugars to the fungi. In turn, the fungi accelerate the breakdown of minerals and the mobilization of nutrients, supporting further tree growth. In some cases, the fungi even release acids that help dissolve minerals, fine-tuning their nutrient-gathering machinery according to the type of nitrogen available.
– Healthy fungal communities can improve forest resilience, nutrient cycling, and carbon storage. My results show how closely mineral breakdown and nitrogen cycling are linked. We need to study these two areas together to better manage forests and help combat climate change, concludes Katharine.
More information
Katharine King will defend her doctoral thesis on Wednesday the 17th of September, at 13.00.
Read the thesis Ectomycorrhizal fungi in boreal forests. Their role in mineral weathering and nitrogen mobilisation